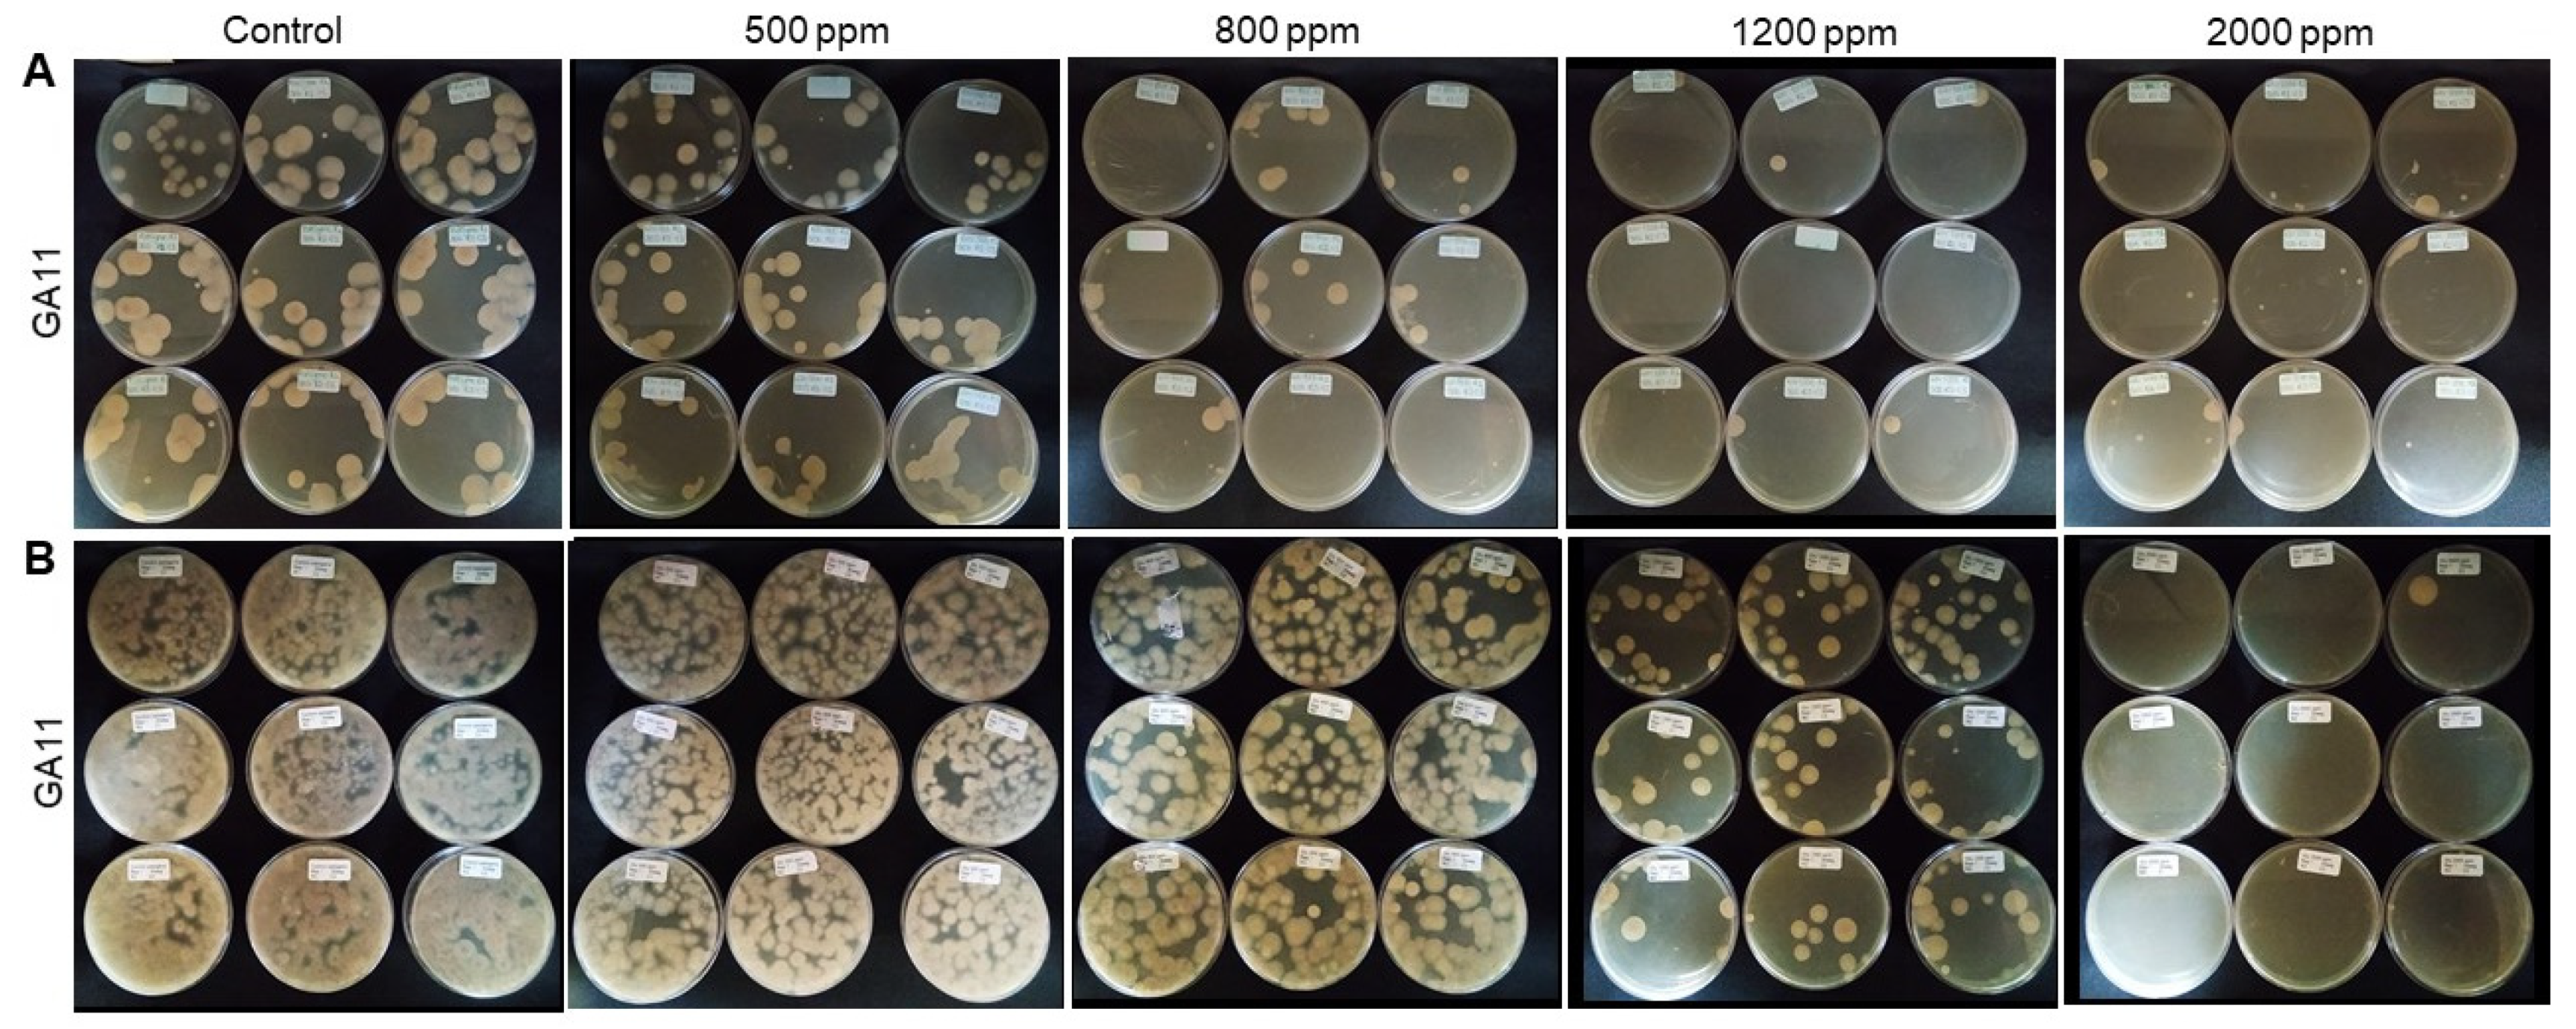

Efficacy of Disinfectants against Fusarium oxysporum f. sp. cubense Tropical Race 4 Isolated from La Guajira, Colombia
Abstract
1. Introduction
2. Material and Methods
2.1. Inoculum Production
2.2. Evaluation of Disinfectants Efficacy on Foc TR4 Propagules in the Absence of Soil
2.3. Evaluation of the Efficacy of Disinfectants on Foc TR4 Propagules in the Presence of Soil
2.4. Experimental Design and Statistical Analysis
3. Results
3.1. Evaluation of Disinfectants Against Foc TR4 Propagules in the Absence of Soil
3.2. Evaluation of Disinfectants Against Foc TR4 Propagules in the Presence of Soil
4. Discussion
5. Conclusions
Supplementary Materials
Author Contributions
Funding
Institutional Review Board Statement
Informed Consent Statement
Data Availability Statement
Acknowledgments
Conflicts of Interest
References
- Bancroft, J. Report of the board appointed to inquire into to the cause of disease affecting livestock and plants. Votes Proc. 1876, 3, 1011–1038. [Google Scholar]
- Hwang, S.C.; Ko, W.H. Cavendish banana cultivars resistant to Fusarium wilt acquired through somaclonal variation. Plant Dis. 2004, 88, 580–588. [Google Scholar] [CrossRef]
- Su, H.J.; Chuang, T.Y.; Kong, W.S. Physiological race of Fusarial wilt fungus attacking Cavendish banana of Taiwan. Taiwan Banan. Res. Int. Spec. Publ. 1977, 2, 1–21. [Google Scholar]
- Ploetz, R.; Freeman, S.; Konkol, J.; Al-Abed, A.; Naser, Z.; Shalan, K.; Barakat, R.; Israeli, Y. Tropical race 4 of Panama disease in the Middle East. Phytoparasitica 2015, 43, 283–293. [Google Scholar] [CrossRef]
- Stover, R.H.; Hildreth, R.C.; Thornton, N.C. Studies on Fusarium Wilt of Bananas: Vii. Field Control. Can. J. Bot. 1961, 39, 197–206. [Google Scholar] [CrossRef]
- Ploetz, R.C. Panama disease: An old nemesis rears its ugly head. APSnet 2005, 6, 18–29. [Google Scholar] [CrossRef]
- Maymon, M.; Shpatz, U.; Harel, Y.; Levy, E.; Teverovsky, E. First report of Fusarium oxysporum f. sp. cubense tropical race 4. Plant Dis. Notes 2018, 98, 694. [Google Scholar] [CrossRef]
- García-Bastidas, F.; Ordóñez, N.; Konkol, J.; Al-Qasim, M.; Naser, Z.; Abdelwali, M.; Salem, N.; Waalwijk, C.; Ploetz, R.C.; Kema, G.H.J. First report of Fusarium oxysporum f. sp. cubense tropical race 4 associated with panama disease of banana outside Southeast Asia. Plant Dis. 2014, 98, 694. [Google Scholar] [CrossRef]
- Ordoñez, N.; García-Bastidas, F.; Laghari, H.; Akkary, M.; Harfouche, E.; Awar, B. First report of Fusarium oxysporum f. sp. cubense tropical race 4 causing Panama disease in Cavendish bananas in Pakistan and Lebanon. Plant Dis. Notes 2015, 100, 209. [Google Scholar] [CrossRef]
- Garcia-Bastidas, F.; Quintero-Vargas, C.; Ayala-Vasquez, M.; Seidl, M.F.; Schermer, T.; Santos-Paiva, M.; Noguera, A.; Aguilera-Galvez, C.; Wittenberg, A.; Hofstede, R.; et al. First report of Fusarium wilt Tropical Race 4 in Cavendish bananas caused by Fusarium odoratissimum in Colombia. Plant Dis. 2019, 1–5. [Google Scholar] [CrossRef]
- Hennessy, C.; Walduck, G.; Daly, A.; Padovan, A. Weed hosts of Fusarium oxysporum f. sp. cubense tropical race 4 in northern Australia. Australas. Plant Pathol. 2005, 34, 115–117. [Google Scholar] [CrossRef]
- Pegg, K.G.; Coates, L.M.; O’Neill, W.T.; Turner, D.W. The Epidemiology of Fusarium Wilt of Banana. Front. Plant Sci. 2019, 10, 1–19. [Google Scholar] [CrossRef] [PubMed]
- Bennett, R.S.; Neill, W.O.; Smith, L.; Hutmacher, R.B. Activity of Commercial Detergents Against Conidia and Chlamydospores of Fusarium oxysporum f. sp. vasinfectum. Plant Pathol. Nematol. 2011, 169, 162–169. [Google Scholar]
- Nguyen, T.V.; Tran-Nguyen, L.T.T.; Wright, C.L.; Trevorrow, P.; Grice, K. Evaluation of the Efficacy of Commercial Disinfectants Against Fusarium Evaluation of the Efficacy of Commercial Disinfectants Against Fusarium oxysporum f. sp. cubense Race 1 and Tropical Race 4 Propagules. Plant Dis. 2019, 103, 721–728. [Google Scholar] [CrossRef]
- Pérez-Sánchez, L.; Sáchez, M.; Carr, C.; Villalta, R.; Guzmán, M. Medidas de Bioseguridad para la Prevención del Marchitamiento por Fusarium Raza 4 Tropical (R4T) en Fincas Bananeras; Corbana: San Jose, CA, USA, 2019. [Google Scholar]
- Dita, M.; Echegoyén Ramos, P.; Pérez Vicente, L. Plan de Contingencia ante un Brote de la Raza 4 Tropical de Fusarium Oxysporum f. sp. Cubense En un País de la Región del OIRSA.; OIRSA: San Salvador, El Salvador, 2013. [Google Scholar]
- ProMusa. ProMusa Tropical Race 4—TR4; ProMusa: Maccarese, Italy, 2014. [Google Scholar]
- Gerba, C.P. Quaternary Ammonium Biocides: Efficacy in Application. Appl. Environ. Microbiol. 2014, 81, 464–469. [Google Scholar] [CrossRef]
- McDonell, G.E. Antisepsis, Disinfection, and Sterilization: Types, Action, and Resistance; Press, A., Ed.; ASM Press: Washington, DC, USA, 2007; ISBN 9781555816445. [Google Scholar]
- Meldrum, R.A.; Daly, A.M.; Tran-nguyen, L.T.T.; Aitken, E.A.B. The effect of surface sterilants on spore germination of Fusarium oxysporum f. sp. cubense tropical race 4. Crop Prot. 2013, 54, 194–198. [Google Scholar] [CrossRef]
- Rutala, W.; Weber, D. Guideline for Disinfection and Sterilization in Healthcare Facilities; CDC: Washington, DC, USA, 2008. [Google Scholar]
- Pineau, L.; Desbuquois, C.; Marchetti, B.; Duc, D.L. Comparison of the fixative properties of five disinfectant solutions. J. Hosp. Infect. 2008, 68, 171–177. [Google Scholar] [CrossRef]
- Brenes, M.; García, A.; De los Santos, B.; Medina, E.; Romero, C.; De Castro, A.; Romero, F. Olive glutaraldehyde-like compounds against plant pathogenic bacteria and fungi. Food Chem. 2011, 125, 1262–1266. [Google Scholar] [CrossRef]
- Altendorf, S. La Marchitez Del Banano Por Fusarium Raza 4 Tropical: ¿Una Creciente Amenza Al Mercado Mundial Del Banano? FAO: Rome, Italy, 2019. [Google Scholar]
- Abbott, W.S. A method of computing the effectiveness of an insecticide. J. Econ. Entomol. 1925, 18, 265–267. [Google Scholar] [CrossRef]
- Martínez-Solórzano, G.E.; Rey-Brina, J.C.; Pargas-Pichardo, R.E.; Enrique-Manzanilla, E. Fusarium wilt by tropical race 4: Current status and presence in the American continent. Agron. Mesoamerican 2020, 31, 259–276. [Google Scholar] [CrossRef]
- Dita, M.; Barquero, M.; Heck, D.; Mizubuti, E.S.G.; Staver, C.P. Fusarium wilt of banana: Current knowledge on epidemiology and research needs toward sustainable disease management. Front. Plant Sci. 2018, 871, 1–21. [Google Scholar] [CrossRef] [PubMed]
- Quintero-Vargas, C.; Delgado, L.E.; Arévalo, E. Conozca Los Procedimientos De Bioseguridad En Las Áreas De Producción De Banano, Plátano Y Heliconias; Organiaztion International Del Trabajo: Geneva, Switzerland, 2018. [Google Scholar]
- Solpot, T.C.; Joseph, C.; Cumagun, R. Control of Fusarium oxysporum f. sp. cubense (E.F. Sm.) Snyder and Hansen tropical race 4 causing Fusarium wilt in banana cv. “Lakatan”. J. Agric. Res. Dev. Ext. Technol. 2019, 25, 21–30. [Google Scholar]
- Nel, B.; Steinberg, C.; Labuschagne, N.; Viljoen, A. Evaluation of fungicides and sterilants for potential application in the management of Fusarium wilt of banana. Crop. Prot. 2007, 26, 697–705. [Google Scholar] [CrossRef]
- Lindsay, S. Fusarium Wilt Tropical Race 4-Biosecurity and Sustainable Solutions Project Leader. 2018. Available online: http://era.daf.qld.gov.au/id/eprint/6540/ (accessed on 14 March 2021).
- Gélinas, P.; Goulet, J. Neutralization of the activity of eight disinfectants by organic matter. J. Appl. Bacteriol. 1983, 54, 243–247. [Google Scholar] [CrossRef] [PubMed]
- Juszkiewicz, M.; Walczak, M.; Mazur-Panasiuk, N. Woźniakowski, G. Effectiveness of Chemical Compounds Used against African Swine Fever Virus in Commercial Available Disinfectants. Pathogens 2020, 9, 878. [Google Scholar] [CrossRef]
- FAO. World Reference Base for Soil Resources 2014: International Soil Classification Systems for Naming Soils and Creating Legends for Soil Maps (Update 2015); FAO: Rome, Italy, 2014; ISBN 978-92-5-108369-7. [Google Scholar]
- Morell, F.; Hernández, A. Degradación de las propiedades agrobiológicas de los suelos ferralíticos rojos lixiviados por la influencia antrópica y su respuesta agroproductiva al mejoramiento. Agron. Trop. 2008, 58, 1–11. [Google Scholar]
- Chandler-Bostock, R.; Mellits, K.H. Efficacy of disinfectants against porcine rotavirus in the presence and absence of organic matter. Lett. Appl. Microbiol. 2015, 6, 538–543. [Google Scholar] [CrossRef] [PubMed]
- Iñiguez-Moreno, M. Resistance of pathogenic and spoilage microorganisms to disinfectants in the presence of organic matter and their residual effect on stainless steel and polypropylene. J. Glob. Antimicrob. Resist. 2018, 14, 197–201. [Google Scholar] [CrossRef] [PubMed]
- Figueroa, A.; Hauck, R.; Saldias-Rodriguez, J.; Gallardo, R.A. Combination of quaternary ammonia and glutaraldehyde as a disinfectant against enveloped and non-enveloped viruses. J. Appl. Poult. Res. 2017, 26, 491–497. [Google Scholar] [CrossRef]
- Takenaka, S.; Tonoki, T.; Taira, K.; Murakami, S.; Aoki, K. Adaptation of Pseudomonas sp. strain 7-6 to quaternary ammonium compounds and their degradation via dual pathways. Appl. Environ. Microbiol. 2007, 73, 1799–1802. [Google Scholar] [CrossRef] [PubMed]
- Tezel, U.; Pavlostathis, S.G. Quaternary ammonium disinfectants: Microbial adaptation, Degradation and ecology. Curr. Opin. Biotechnol. 2015, 33, 296–304. [Google Scholar] [CrossRef] [PubMed]
- FAOSTAT. Production—Crops—Area harvested/Production Quantity—Tomatoes—2014. Available online: http://www.fao.org/faostat/en/#data/QC (accessed on 14 March 2021).
- ANALDEX. Informe de Exportaciones de Fruta. Available online: https://www.analdex.org/2019/07/31/informe-de-exportaciones-de-fruta-enero-mayo-2019 (accessed on 14 March 2021).

| Disinfectant (Treatments) Ψ | Active Ingredient * | QAC Generation |
|---|---|---|
| QAC1_1st | Benzalkonium chloride | 1st |
| QAC2_1st | Benzalkonium chloride | 1st |
| QAC3_1st | Benzalkonium chloride | 1st |
| QAC4_1st | Benzalkonium chloride | 1st |
| QAC5_4th | Dimethyl ammonium chloride | 4th |
| QAC6_4th | Didecyldimethylammonium chloride | 4th |
| QAC7_4th | Benzalkonium chloride+Didecyldimethylammonium chloride | 4th |
| QAC8_5th | Di(octyl/decyl) chloride + dimethyl ammonium + benzalkonium chloride | 5th |
| QAC9_5th | Quaternary ammonium | 5th |
| QAC10_5th | Quaternary ammonium | 5th |
| GA11 a | Glutaraldehyde | - |
Publisher’s Note: MDPI stays neutral with regard to jurisdictional claims in published maps and institutional affiliations. |
© 2021 by the authors. Licensee MDPI, Basel, Switzerland. This article is an open access article distributed under the terms and conditions of the Creative Commons Attribution (CC BY) license (https://creativecommons.org/licenses/by/4.0/).
Share and Cite
Izquierdo-García, L.F.; Carmona, S.L.; Zuluaga, P.; Rodríguez, G.; Dita, M.; Betancourt, M.; Soto-Suárez, M. Efficacy of Disinfectants against Fusarium oxysporum f. sp. cubense Tropical Race 4 Isolated from La Guajira, Colombia. J. Fungi 2021, 7, 297. https://doi.org/10.3390/jof7040297
Izquierdo-García LF, Carmona SL, Zuluaga P, Rodríguez G, Dita M, Betancourt M, Soto-Suárez M. Efficacy of Disinfectants against Fusarium oxysporum f. sp. cubense Tropical Race 4 Isolated from La Guajira, Colombia. Journal of Fungi. 2021; 7(4):297. https://doi.org/10.3390/jof7040297
Chicago/Turabian StyleIzquierdo-García, Luisa F., Sandra L. Carmona, Paola Zuluaga, Gustavo Rodríguez, Miguel Dita, Mónica Betancourt, and Mauricio Soto-Suárez. 2021. "Efficacy of Disinfectants against Fusarium oxysporum f. sp. cubense Tropical Race 4 Isolated from La Guajira, Colombia" Journal of Fungi 7, no. 4: 297. https://doi.org/10.3390/jof7040297
APA StyleIzquierdo-García, L. F., Carmona, S. L., Zuluaga, P., Rodríguez, G., Dita, M., Betancourt, M., & Soto-Suárez, M. (2021). Efficacy of Disinfectants against Fusarium oxysporum f. sp. cubense Tropical Race 4 Isolated from La Guajira, Colombia. Journal of Fungi, 7(4), 297. https://doi.org/10.3390/jof7040297

